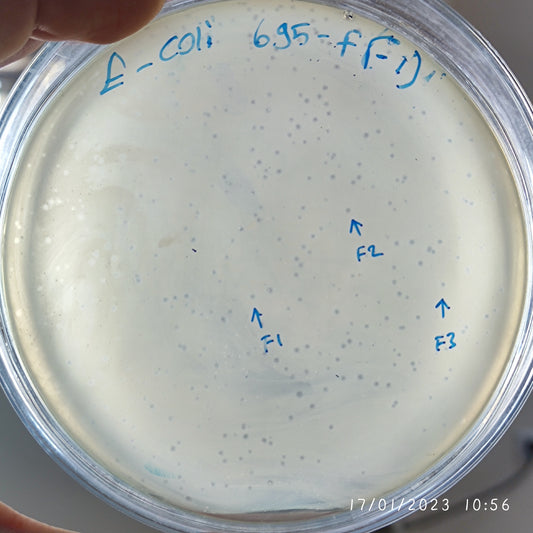
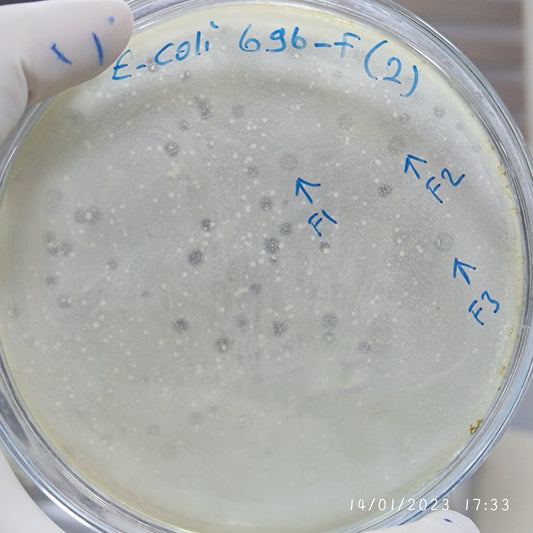
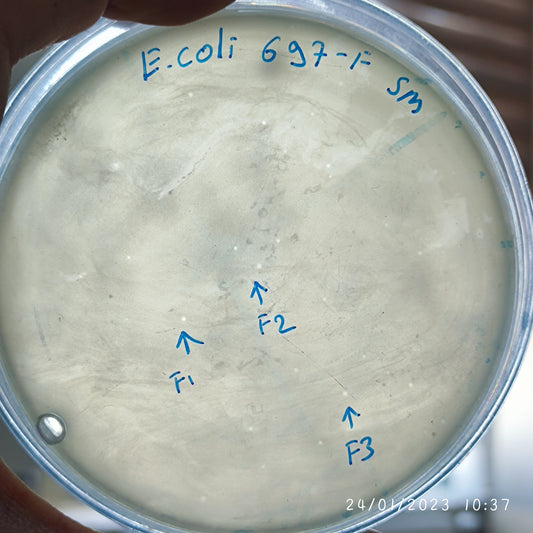
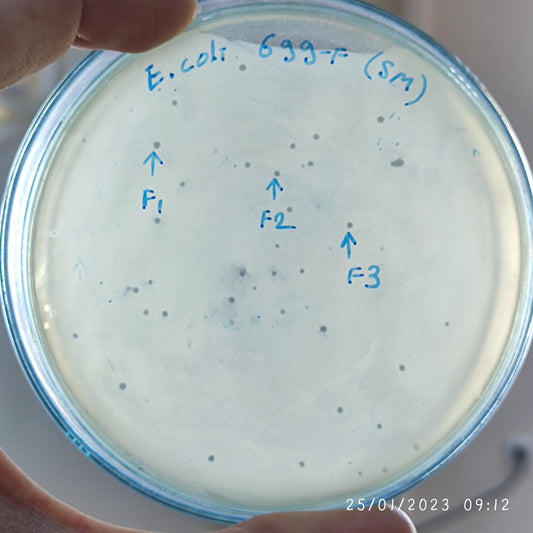
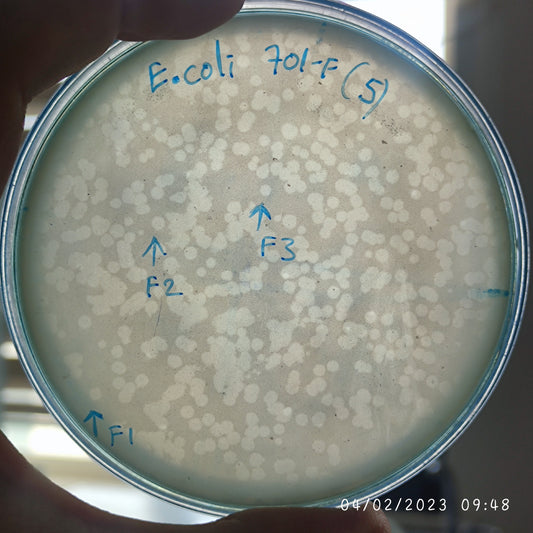
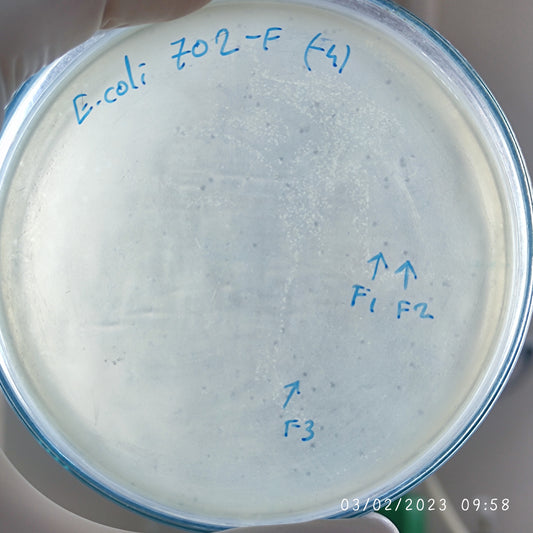
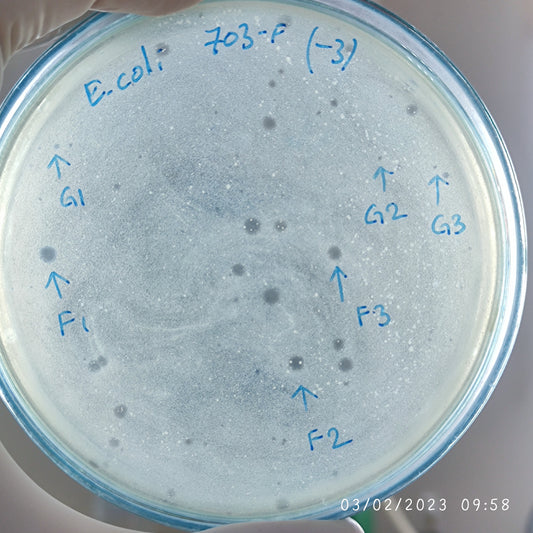
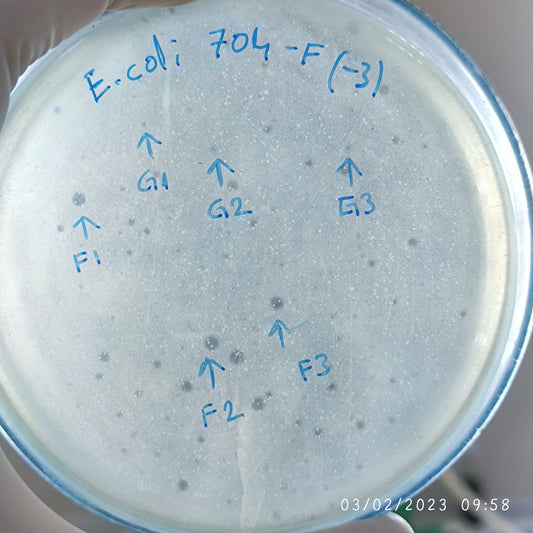
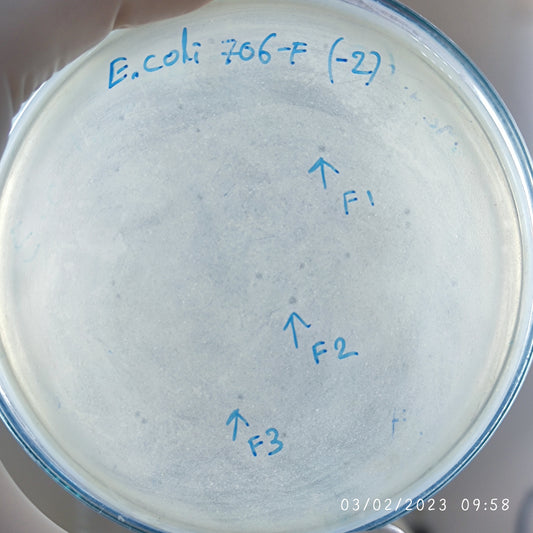
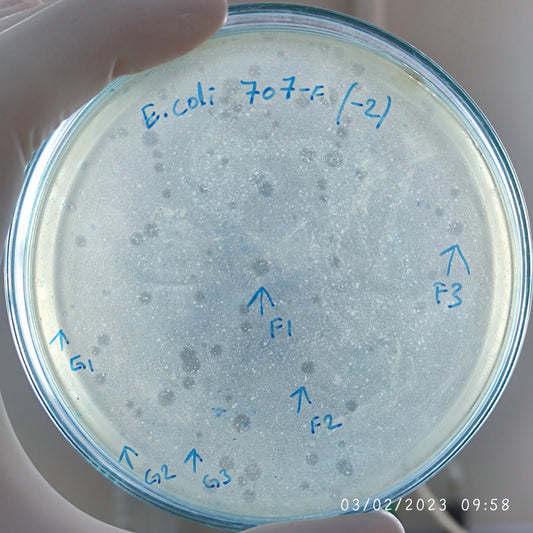
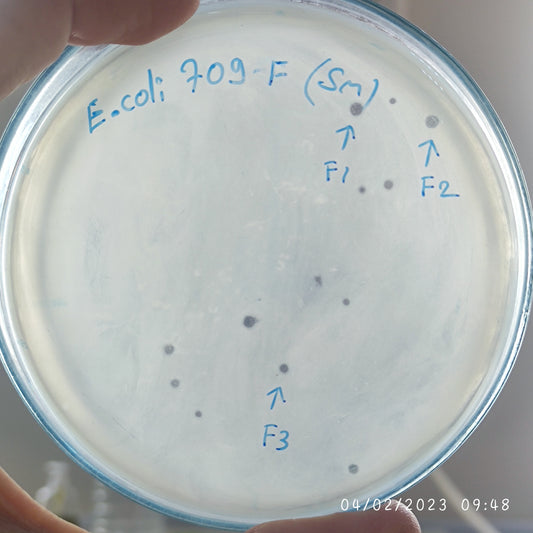
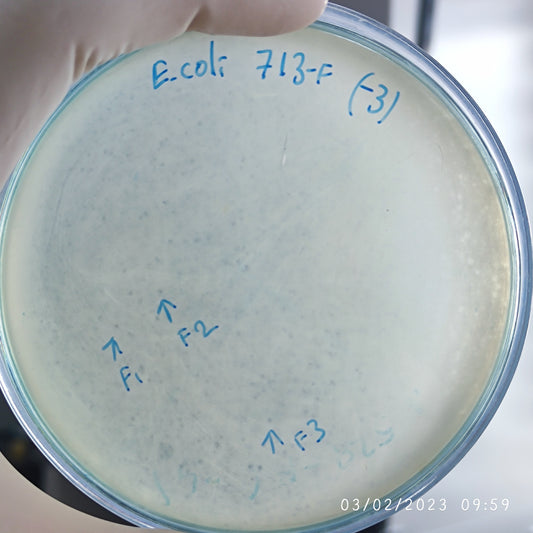
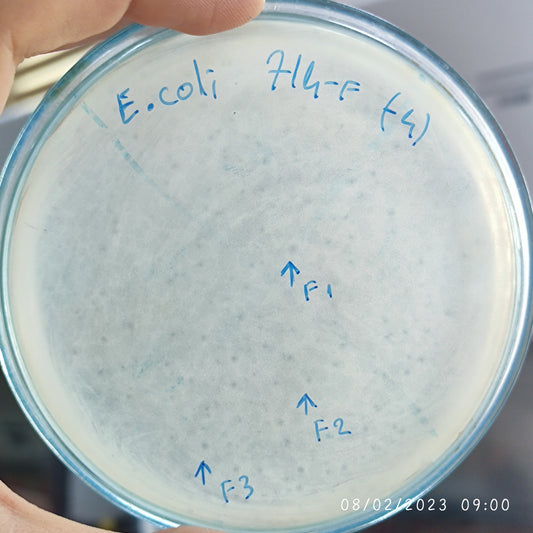

-
Escherichia coli bacteriophage 100695F
Regular price $700.00 USDRegular priceUnit price per -
Escherichia coli bacteriophage 100696F
Regular price $500.00 USDRegular priceUnit price per -
Escherichia coli bacteriophage 100697F
Regular price $600.00 USDRegular priceUnit price per -
Escherichia coli bacteriophage 100699F
Regular price $750.00 USDRegular priceUnit price per -
Escherichia coli bacteriophage 100701F
Regular price $700.00 USDRegular priceUnit price per -
Escherichia coli bacteriophage 100702F
Regular price $600.00 USDRegular priceUnit price per -
Escherichia coli bacteriophage 100703F
Regular price $600.00 USDRegular priceUnit price per -
Escherichia coli bacteriophage 100703G
Regular price $600.00 USDRegular priceUnit price per -
Escherichia coli bacteriophage 100704F
Regular price $700.00 USDRegular priceUnit price per -
Escherichia coli bacteriophage 100704G
Regular price $700.00 USDRegular priceUnit price per -
Escherichia coli bacteriophage 100706F
Regular price $700.00 USDRegular priceUnit price per -
Escherichia coli bacteriophage 100707F
Regular price $700.00 USDRegular priceUnit price per -
Escherichia coli bacteriophage 100707G
Regular price $700.00 USDRegular priceUnit price per -
Escherichia coli bacteriophage 100709F
Regular price $750.00 USDRegular priceUnit price per -
Escherichia coli bacteriophage 100713F
Regular price $600.00 USDRegular priceUnit price per -
Escherichia coli bacteriophage 100714F
Regular price $600.00 USDRegular priceUnit price per